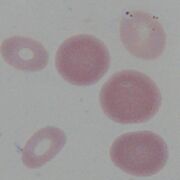
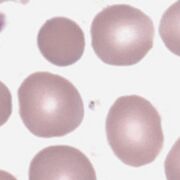
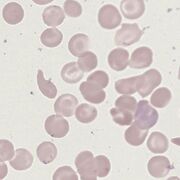
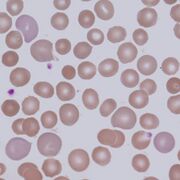
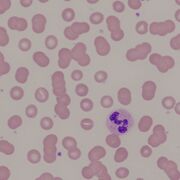
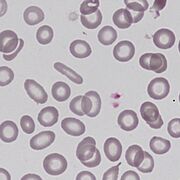
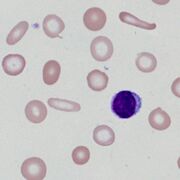
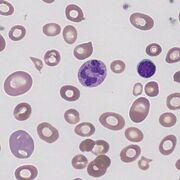

Uploads by John
This special page shows all uploaded files.
| Date | Name | Thumbnail | Size | Description | Versions |
|---|---|---|---|---|---|
| 19:34, 26 March 2023 | TD1A.png (file) |  |
98 KB | 1 | |
| 19:08, 26 March 2023 | DM2A.jpg (file) | |
51 KB | 2 | |
| 18:57, 26 March 2023 | PolyC1A.png (file) |  |
90 KB | 1 | |
| 19:38, 24 March 2023 | NRBC1C.png (file) |  |
65 KB | 1 | |
| 19:35, 24 March 2023 | NRBC1B.png (file) |  |
106 KB | 1 | |
| 19:33, 24 March 2023 | NRBC1A.png (file) |  |
119 KB | 1 | |
| 11:28, 24 March 2023 | SC1A.png (file) |  |
106 KB | 1 | |
| 19:11, 23 March 2023 | Rou0.png (file) |  |
135 KB | 1 | |
| 19:09, 23 March 2023 | SC0.png (file) |  |
44 KB | 1 | |
| 19:06, 23 March 2023 | HypoC0a.png (file) |  |
98 KB | 1 | |
| 19:01, 23 March 2023 | PolyC0.png (file) |  |
91 KB | 1 | |
| 18:57, 23 March 2023 | Nrbc0.png (file) |  |
105 KB | 1 | |
| 18:44, 23 March 2023 | Aniso0.png (file) |  |
135 KB | 1 | |
| 18:40, 23 March 2023 | AnisoC0.png (file) |  |
124 KB | 1 | |
| 18:21, 23 March 2023 | HypoC0.png (file) |  |
166 KB | 1 | |
| 18:21, 23 March 2023 | Mac0.png (file) |  |
145 KB | 1 | |
| 16:50, 23 March 2023 | St0.png (file) |  |
57 KB | 1 | |
| 14:30, 23 March 2023 | St5.jpg (file) |  |
99 KB | 1 | |
| 14:29, 23 March 2023 | St4.jpg (file) |  |
112 KB | 1 | |
| 14:29, 23 March 2023 | St3.jpg (file) |  |
119 KB | 1 | |
| 14:29, 23 March 2023 | St2.jpg (file) |  |
50 KB | 1 | |
| 14:28, 23 March 2023 | St1.png (file) |  |
187 KB | 1 | |
| 14:25, 23 March 2023 | SP4.jpg (file) |  |
80 KB | 1 | |
| 14:25, 23 March 2023 | SP3.jpg (file) |  |
72 KB | 1 | |
| 14:25, 23 March 2023 | SP2.jpg (file) | |
43 KB | 1 | |
| 14:24, 23 March 2023 | SP1.png (file) |  |
125 KB | 1 | |
| 14:10, 23 March 2023 | SCP4.jpg (file) | |
69 KB | 1 | |
| 14:10, 23 March 2023 | SCP3.jpg (file) |  |
71 KB | 1 | |
| 14:09, 23 March 2023 | SCP2.jpg (file) |  |
46 KB | 1 | |
| 14:09, 23 March 2023 | SCP1.png (file) |  |
77 KB | 1 | |
| 14:07, 22 March 2023 | PolyC4.jpg (file) |  |
56 KB | 1 | |
| 14:07, 22 March 2023 | PolyC3.jpg (file) | |
56 KB | 1 | |
| 14:07, 22 March 2023 | PolyC2.jpg (file) |  |
29 KB | 1 | |
| 14:07, 22 March 2023 | PolyC1.png (file) |  |
82 KB | 1 | |
| 14:00, 22 March 2023 | Rou4.jpg (file) | |
218 KB | 1 | |
| 13:59, 22 March 2023 | Rou3.jpg (file) |  |
58 KB | 1 | |
| 13:59, 22 March 2023 | Rou2.jpg (file) |  |
58 KB | 1 | |
| 13:59, 22 March 2023 | Rou1.png (file) |  |
142 KB | 1 | |
| 13:50, 22 March 2023 | Pen4.jpg (file) | |
62 KB | 1 | |
| 13:50, 22 March 2023 | Pen3.jpg (file) | |
45 KB | 1 | |
| 13:50, 22 March 2023 | Pen2.jpg (file) |  |
33 KB | 1 | |
| 13:50, 22 March 2023 | Pen1.png (file) |  |
91 KB | 1 | |
| 13:47, 22 March 2023 | PH4.jpg (file) |  |
36 KB | 1 | |
| 13:47, 22 March 2023 | PH3.jpg (file) |  |
48 KB | 1 | |
| 13:47, 22 March 2023 | PH2.jpg (file) |  |
27 KB | 1 | |
| 13:46, 22 March 2023 | PH1.png (file) |  |
72 KB | 1 | |
| 13:44, 22 March 2023 | Ova5.jpg (file) | |
103 KB | 1 | |
| 13:44, 22 March 2023 | Ova4.jpg (file) |  |
80 KB | 1 | |
| 13:43, 22 March 2023 | Ova3.jpg (file) |  |
81 KB | 1 | |
| 13:43, 22 March 2023 | Ova2.jpg (file) |  |
47 KB | 1 |